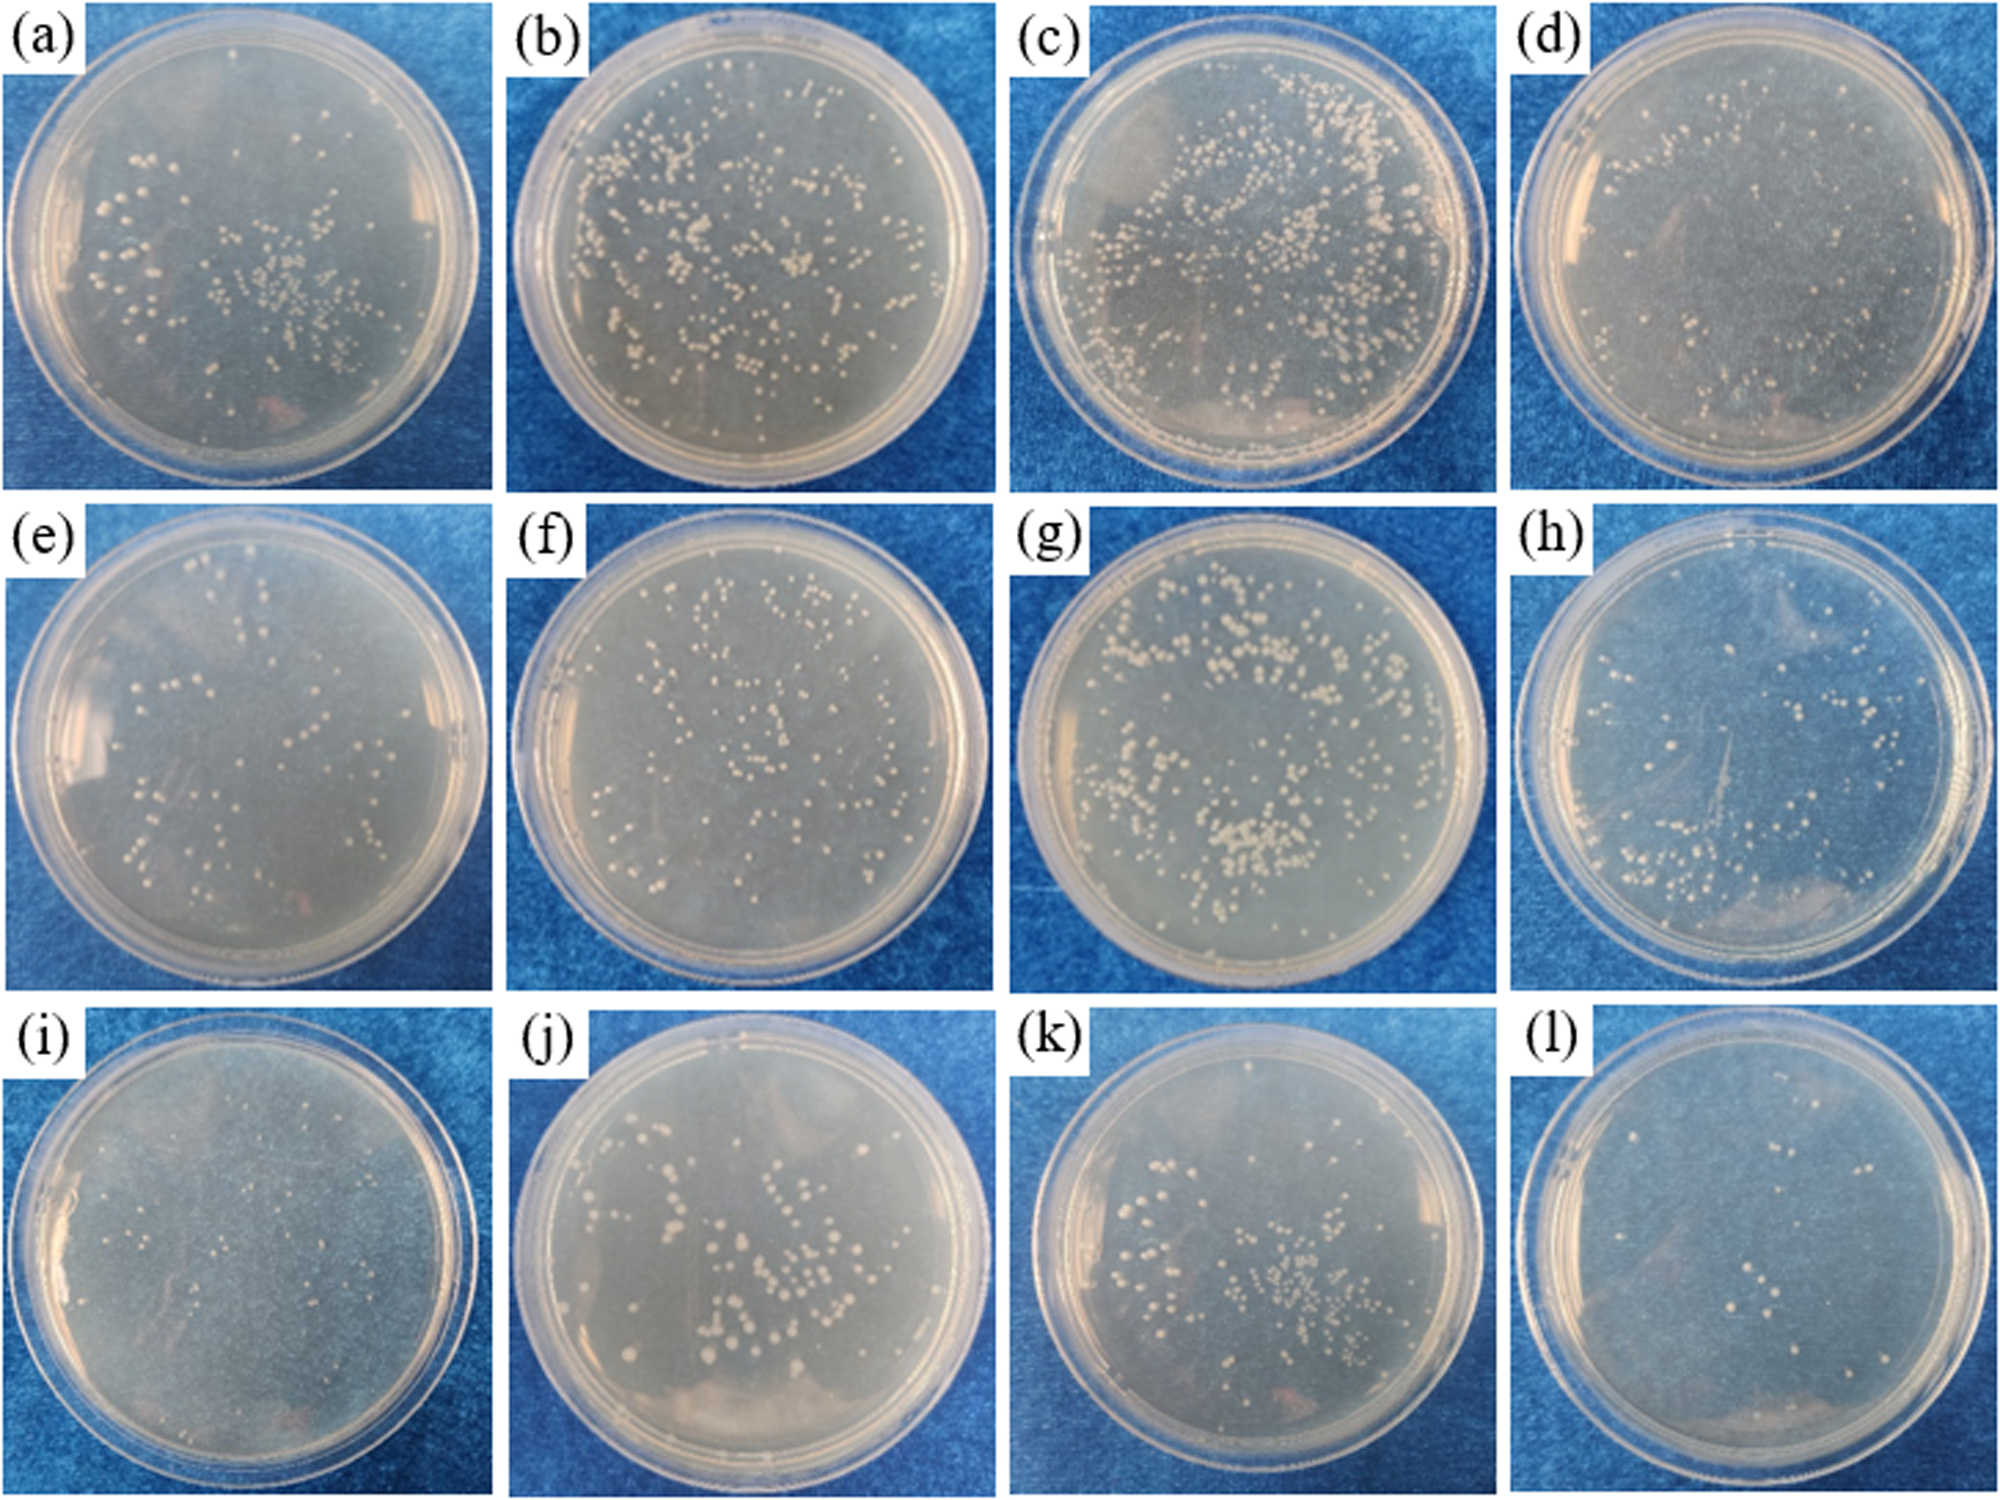
Fig. 8

Fig. 8: The colonies of B. cereus cultured from the biofilm samples collected from different Cu-bearing steels.
a–d 0.0Cu, e–h 0.6Cu, i–l 1.0Cu, (a, e, i), (b, f, j), (c, g, k) and (d, h, l) are cultured 1, 3, 7 and 14 days respectively (105 cfu·cm−2).
